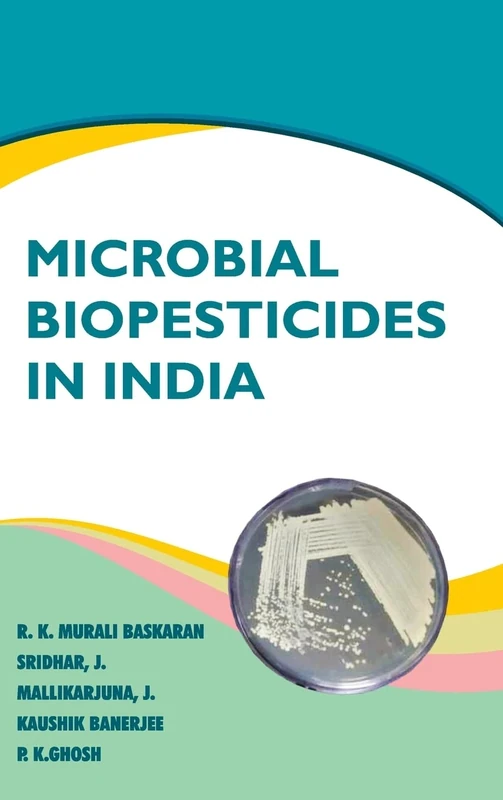
Microbial Biopesticides in India

We can't find the internet
Attempting to reconnect
Something went wrong!
Hang in there while we get back on track

£72.57
NIPA Food Adulterants and Contaminants
Price data last checked 97 day(s) ago - refreshing...
We'll watch every seller, every day. One email when your price arrives.
This is the most expensive it has ever been. Walk away.
£73 today · previous high £73 · all-time low £70
NEW HERE?
Amazon shows you one price. We show you all of them.
Tosheroon watches Amazon prices so you don't have to. Every product on Amazon has a price history — we make it visible. Set the price you'd actually pay, and we'll email you the second it gets there. No app, no account, one email.
WHAT'S ON THIS PAGE
when this has been cheap or pricey
where the price is heading next
all-time high & low, recent range
name your number, we'll email you
Price History & Forecast
Grey patches = out of stock. Cheaper = lower on the chart. Hover for exact prices.
Last 32 days • 32 data points (No recent data available)
Price Distribution
Price distribution over 32 days • 2 price levels
Price Analysis
Most common price: £70 (28 days, 87.5%)
Price range: £70 - £73
Price levels: 2 different prices over 32 days
Product Specifications
- Brand
- NIPA
- Format
- Hardcover
- ASIN
- 8119235045
- Domain
- Amazon UK
- Release Date
- 24 May 2024
- Listed Since
- 24 November 2023
Barcode
No barcode data available
Similar Products You Might Like

Food Science
NIPA

Phytochemical Techniques
NIPA

Novel Food Processing Technologies
NEW INDIA PUBLISHING AGENCY- NIPA

Processing and Value Addition of Horticultural Crops
NIPA

Innovations in Food Processing Technology
NEW INDIA PUBLISHING AGENCY- NIPA

Naturally Occurring Bioactive Compounds
Elsevier

Crop Trials with R
New India Publishing Agency – NIPA

Fundamentals of Ornamentals Horticulture and Landscape Gardening
NIPA

ADHD and Developmental Disabilities
Foster Academics

Learning Disabilities: Assessment and Intervention
Foster Academics

Glasnost, Perestroika, and the Socialist Community
ABC-CLIO

COVID-19 and African Borders in Transition
MACMILLAN

Emerging Technologies and the Indian IT Sector
CRC Press

Renewing America's Cities
By

Gendered Experiences of COVID-19 in India
MACMILLAN

Internet of Things (Iot) Enabled Automation in Agriculture
NIPA

Characters and Commentaries
By

Resource Efficiency, Sustainability, and Globalization: Exploring India-European Union Cooperation
CRC Press
Microbial Biopesticides in India

Labor Commitment and Social Change in Developing Areas
By

Insect Pests of Vegetable, Spices and Ornamental Crops: Identification and Management
NIPA

Artificial Intelligence and Hybrid Systems
CREATESPACE

Arsenic Exposure and Health Effects III
Elsevier

Social Provision in Rural Wiltshire (Routledge Revivals)
Routledge